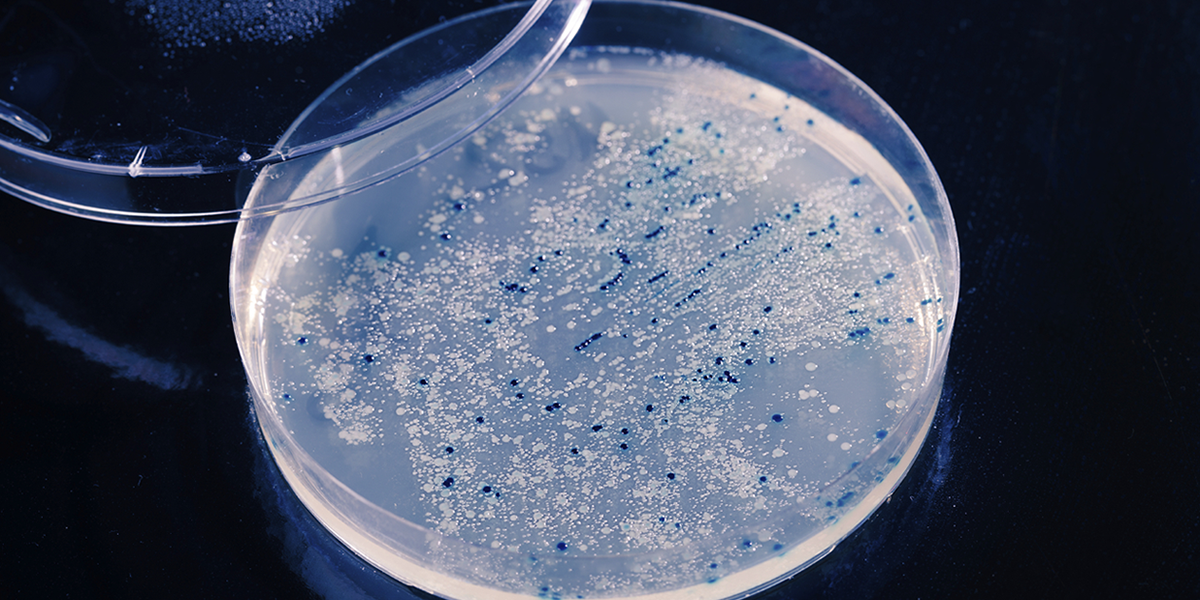

Winnen we de oorlog tegen resistente bacteriën?
februari 28, 2018
Als dé oplossing tegen resistente bacteriën worden tegenwoordig vaak bacteriofagen genoemd: dat zijn virussen die geen mensen ziek maken maar juist de bacteriën aanvallen waar mensen ziek van worden. Wetenschappers die onderzoek doen tegen resistentie twijfelen of deze bacteriofagen echt dé oplossing zijn. Zij gaan liever op zoek naar andere antibiotica, maar het is nog maar de vraag of ze die op tijd gaan vinden. De resistente bacteriën zijn in opkomst en de ontwikkeling van nieuwe medicijnen gaat nog lang niet snel genoeg.
Lees meer over bacteriofagen op de website van Nemo Kennislink: https://www.nemokennislink.nl/publicaties/winnen-we-de-oorlog-tegen-resistente-bacterien/
Bron: Nemo Kennislink
Datum: 21 februari 2018


